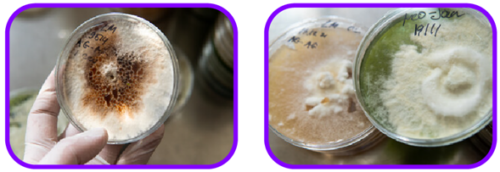

¿Qué medios puedo emplear?

Las infecciones asociadas a la atención de la salud y adquiridas en la comunidad ha aumentado dramáticamente.
Las alteraciones en el huésped, particularmente las personas inmunocomprometidas son el factor principal en el aumento de infecciones por hongos.
La mayoría de estos organismos son saprófitos (viven en materia orgánica descompuesta) en la naturaleza.
Los hongos que se obtienen en los cultivos en el laboratorio clínico generalmente se pueden clasificar en dos grupos según la apariencia de las colonias formadas. Las levaduras producen humedad, colonias cremosas, opacas o pastosas en los medios, mientras que los hongos filamentosos o mohos producen colonias esponjosas, algodonosas, lanosas o polvorientas.
Varios hongos sistémicos que exhiben una forma de levadura y levaduras en fase filamentosa se conocen como dismórficos.
Cuando el dimorfismo depende de la temperatura, los hongos son designados como térmicamente dismórficos. En general, estos hongos producen una forma de moho a 25°C a 30°C y una forma de levadura a 35°C a 37°C bajo ciertas circunstancias.
Los hongos están compuestos por una gran variedad de organismos que son únicos en comparación con las plantas y los animales.
A pesar de su gran variación en características morfológicas, la mayoría de los hongos comparten las siguientes características:
- Quitina en la pared celular.
- Ergosterol en la membrana celular.
- Reproducción por medio de esporas, producidas asexual o sexualmente.
- Falta de clorofila.
- Falta de susceptibilidad a los antibióticos antibacterianos.
- Naturaleza saprofita (derivar la nutrición de materiales orgánicos.

Acorde al esquema médico, las infecciones por hongos las podemos dividir en cuatro categorías:
- Micosis superficiales (cutáneas).
- Micosis subcutáneas.
- Micosis sistémicas.
- Micosis oportunistas.
El diagnóstico de infecciones fúngicas depende completamente de la selección y recolección de una muestra clínica apropiada para análisis microscópico y cultivo.
Varios medios de cultivo para hongos son satisfactorios para su uso en el laboratorio de microbiología clínica. Para una recuperación óptima, se debe utilizar una batería de medios de cultivo, para los cual los siguientes son recomendados:
- Medios con y sin cicloheximida para prevenir el sobrecrecimiento de hongos de crecimiento lento por especies de crecimiento más rápido. Es importante tener en cuenta que la cicloheximida también puede ser inhibitorio para algunos hongos. El Agar Hongos y Agar Hongos dermatofitos proporcionan estas características para la recuperación fúngica.
- Medios con y sin agente antibacteriano (medios con un agente antibacteriano se utilizan para muestras que probablemente contiene bacterias contaminantes; no son necesarios para muestras de sitios estériles).
- El agar inhibidor controla más la contaminación bacteriana eficaz que el agar dextrosa Sabouraud; sin embargo, este medio permite la recuperación tanto de levaduras como de hongos tipo moho apropiada para pruebas de identificación por métodos bioquímicos, espectrometría de masa y pruebas de fungigrama.
- El cloranfenicol se usa a menudo como un agente inhibidor para el crecimiento de bacterias contaminantes; sin embargo, es importante señalar que también inhibe Nocardia y otros actinomicetos aerobios. Este antibiótico se encuentra comúnmente en los medios Agar Sabouraud Cloranfenicol y Agar Patata Dextrosa con Cloranfenicol.
- El crecimiento de hongos dimórficos mejora en medios enriquecidos como Agar BHI que contiene antibióticos y 5% a 10% de sangre de oveja. Esto mejora el crecimiento, pero inhibe la esporulación. Una vez aislados, los hongos deben subcultivarse inmediatamente en medios enriquecidos sin sangre para identificación. El Agar Sabouraud Dextrosa es un medio apropiado para esta fase de recuperación.
- Se puede usar agar cromogénico específico para identificar alguna especie de levadura. Actualmente el CHROMagar candida plus permite la identificación de las diferentes especies de Candida incluyendo C. auris.